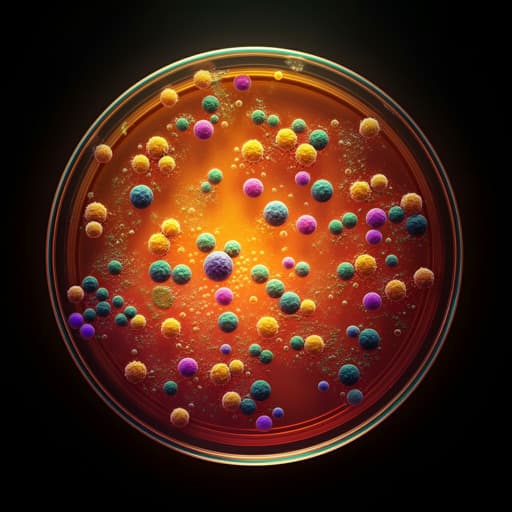
Effects of ketogenic diet on the classification and functional composition of intestinal flora in children with mitochondrial epilepsy

Medicine and Health
Effects of ketogenic diet on the classification and functional composition of intestinal flora in children with mitochondrial epilepsy
J. Wang, L. Huang, et al.
This groundbreaking study explores how a ketogenic diet transforms the gut microbiota in children with mitochondrial epilepsy. The researchers observed significant shifts in bacterial composition, indicating potential biomarkers for the therapeutic benefits of the diet. Insights from this research were brought to light by a team of experts including Jing Wang and Lijuan Huang from Wuhan Children's Hospital.
Playback language: English
Related Publications
Explore these studies to deepen your understanding of the subject.